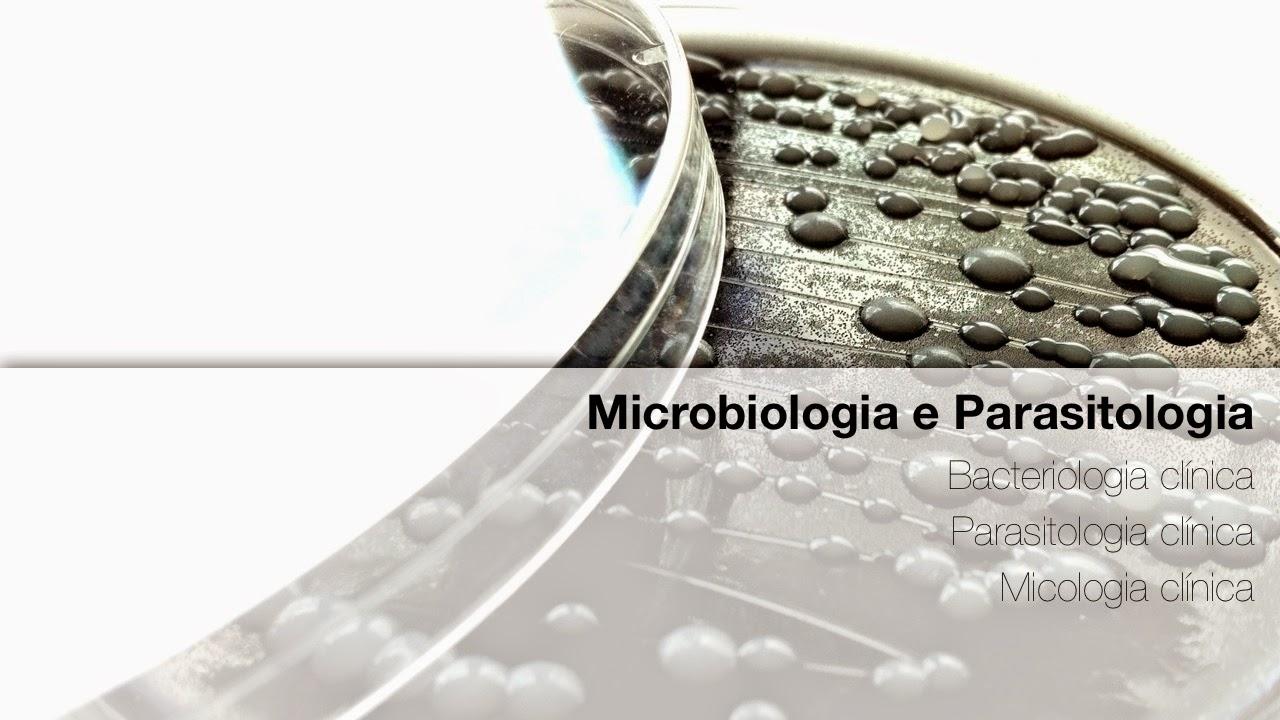
Foto 5

Axys Análises - Laboratório Veterinário e Consultoria Diagnóstica
Auxiliadora Porto Alegre RS
(3 avaliações)
Clínica Veterinária
Veterinary Clinic
Por que escolher Axys Análises - Laboratório Veterinário e Consultoria Diagnóstica? É uma excelente opção em Porto Alegre, com nota média de 5 estrelas.
Faça login para deixar sua avaliação
EntrarAvaliações
Daniel Muller
2017-05-18
Lucas Turk
2017-03-04
Muito Bom!!
Eduardo Masuda
2016-05-24
Ver Endereço
Auxiliadora, Porto Alegre, RS
Ver Telefone
(51) 30625-101
Como Chegar
Prestador não existe
Pet Shops Próximos

Petit Pet Boutique
Auxiliadora Porto Alegre RS
(5)

Bicho Pet Store
Auxiliadora Porto Alegre RS
(5)

Gaia Veterinary Clinic
Auxiliadora Porto Alegre RS
(5)